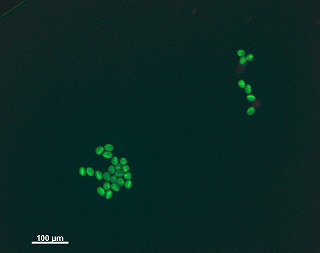

| Status |
| Plasmid construction | -> done |
| Plasmid construction | -> done |
| Transformed | -> done |
| T1 seed harvested | -> done |
| T2 seed harvested | -> done |
|
CRES-T phenotype from individual project
View all photo |
dwarf (08221),
viviparous (direct input),
sterile or low fertility (07561, direct input, 08221)
and more... and more... |
| CRES-T phenotype from publication |
|
| CRES-T phenotype from bulk project |
sterile or low fertility
(A107462-57)
|
Phenotype in ornamental plants
|
|
| Comment |
|
